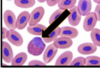
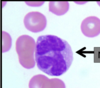
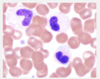
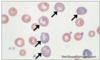
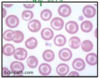
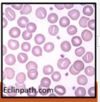
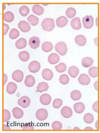
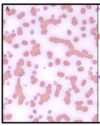
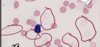

Cell identification (Blood Smear) Flashcards
(35 cards)
Identify the cells in this smear.
List the function of them.

Basophils
- These are rare to find in circulation in a healthy animals.
Major Function: hypersensitivity, balance eosinophil reactions.
Identify the cell in this smear
List the major function, and any notable identifying features

Eosinophil
Major function- response to allergens, parasites, hypersensitivity.
Granulocyte with orange-red-pink staining granules; often round but more elongate in cats.
sighthounds have faded “grey eosinophils” (Do not confuse with toxic neutrophils)
Identify the cell in this smear.
List the major function, and any key identifying features
Heterophil
The cytoplasm contains numerous red-orange oval, needle, or rice-shaped granules.
In Birds and Reptiles, have these rather than neutrophils
These cells lack myeloperoxidase (breaks down exudate). This explains why birds have more of a caseous exudate in infections
Identify the cell in this smear.
List the major function, and any key identifying features

Lymphocyte
Major function: immunogenic.
This is the predominant leukocyte in:
- adult ruminants (primary cell)
- some bird and reptile species.
Identification- thin rim of blue cytoplasm
Identify the cell in this smear.
List the major function, and any key identifying features
Monocyte
Major function: 2nd line of defense for infections, immunogenic
Typically a large cell witih cytoplasm that is blue to blue-gray,
** often vacuoles form in EDTA**
- Can be difficult to differentiate from immature neutrophils
Identify the cell in this smear.
List the major function, and any key identifying features

Immature Neutrophil
Major function: first line of defense against pathogenic bacteria.
Identification: the more basophilic staining cytoplasm= more RNA
-this is the most common leukocyte in healthy dogs, cats, horses, primates
The more common immature neutrophils are, is indicative of how intense the tissue demand is.
Identify this cell
List the major functions as well as any key identifying features

Mature neutrophil
Function: first line of defense against pathogenic bacteria.
This is the most numerous leukocyte in healthy dogs, cats, horses, primates.
Incraesed WBC on a smear
Leukocytosis
Decreased WBC concentration on Smear
Leukopenia
What are granulocytes?
Neutrophils, eosinophils, and basophils
these have segmented nucleus
Leukocytes with cytoplasmic granules may or may not be visible
What is Pelger-Huet Anomally
This is an inherited blood condition, where the nuclei of several types of white blood cells have hyposegmentation with band or peanut shape with mature nuclear chromatin
- the image here is from a neutrophil affected by this condition
- Can be mistaken for bands leading to misdiagnosis of inflammation and/or infection
Seen in Australian Shepherds, foxhounds, Samoyeds and mixed breed dogs
Identify this cell type
List any key identifying features as well as additional important information

These cells with the long arrow are aggregate reticulocytes.
These cells correspond to polychromatophils on blood smear stained with Wright’s type stain.
These cells are found in circulation in response to a regenerative anemia.
List the name of this cell on a smear
Include the major function, or any key features of this cell type

Punctate Reticulocyte
These cells persist in circulation for several weeks-> therefore not a good indicator of current regenerative response
Identify the features of this cell on a smear
list the key functions, or conditions it is seen in
Basophilic Stippling
- Spontaneous aggregation of ribosomal RNA in RBC cytoplasm
This may be seen with:
- regeneration (especially in ruminants)
- Lead poisioning (also would expect an increased number of nucleated RBC)
Identify the type of cell on the smear
Include any major functions, or conditions associated with this type of cell.

Echinocytes (“Crenated Cell” or “Burr cells”)
These are spiculated RBC with evenly distributed, short projections
Artifactual causes: Excess EDTA, RBC dehydration, Increased pH, Aged blood
Disease processes: Electrolyte depletion from sweating diarrhea etc. Renal Disease, PK deficiency, snake envenomation
-Most commonly artifactual, but it is worth noting
List the type of cell in this smear
Include major function, and major disease processes
Codocytes “Target Cells”
These cells have increased surface to volume ratio
This is only observed in dogs.
Often associated with regenerative anemia
- Also cseen with iron deficiency anemia, liver disease, hypothyroidism in dogs
Identify the cell
Include major disease processes, and identifying features
Stomatocyttes
-RBC with elongated central pallor
Can be seen with regenerative anemia
- Can be artifactual - Smear too thick
identify the cell type
Include any major disease process or identifying features

Drepanocytes
-Sickle-shaped RBC’s
This occurs in some types of deer, antelope, sheep, goats, mongoose, and genet
Occurs due to variants in hemoglobin after exposure to atmospheric O2 or with alkalosis
Identify the cell type
Include the disease process and identifying features

Ovalocytes/Elliptocytes
Elongated RBC
-can be artifactual in the creation of the smear
Diseases:
- Liver disease
Myelofibrosis in dogs
- Bone marrow disease
Identify the cell type
Include major disease processes/ key identifying features
Howell-Jolly bodies
Small fragment of nuclear matierial not extruded as the erythrocyte left the bone marrow (usually one per RBC)
Can be seen in low numbers in cats, or horses
Increased number may occur with corticosteroid administration or after splenectomy
identify the cell type
Include major disease processes or identifying features

Dacrocytes
-Tear dropped shaped RBC’s
Can be created artifactually during smear preparation
May be seen in animals with bone marrow diseases such as myelofibrosis or neoplasia
What types of RBC will you see in hemolytic anemia?
Spherocytes, ghost cells, RBC agglutination
Identify the cell type
include major disease processes associated with this
Rouleaux
- RBCs form a stack of coins
- normal finding in horses and cats
- forms with increased fibrinogen and/or immunoglobulins
-Inflammation
- Neoplasms associated with monoclonal gammopathies
Identify the cell type/condition
Include major disease processes
Agglutination
RBC grouped like a cluster of grapes
Can artifactually increase the MCV
Difficult to distinguished form severe rouleaux
- Immune mediated hemolysis